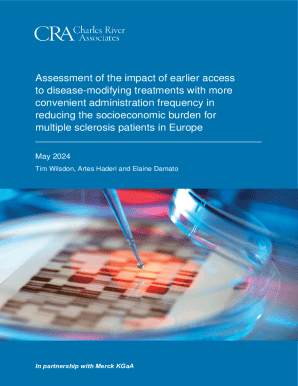

Get the free Apa yang dimaksud dengan Transaksi Repurchase Agreement
Show details
TANYA JA WAB PERTURB STORIES NASA REAGAN
NOOR: 09/POJK.04/2015 TENTING YEOMAN TRANSPOSE REPURCHASE
AGREEMENTBAGI LAMBADA NASA REAGAN
1. APA yang damasked began Transpose Repurchase Agreement?
Jaw
We are not affiliated with any brand or entity on this form
Get, Create, Make and Sign apa yang dimaksud dengan

Edit your apa yang dimaksud dengan form online
Type text, complete fillable fields, insert images, highlight or blackout data for discretion, add comments, and more.

Add your legally-binding signature
Draw or type your signature, upload a signature image, or capture it with your digital camera.

Share your form instantly
Email, fax, or share your apa yang dimaksud dengan form via URL. You can also download, print, or export forms to your preferred cloud storage service.
Editing apa yang dimaksud dengan online
In order to make advantage of the professional PDF editor, follow these steps below:
1
Log in. Click Start Free Trial and create a profile if necessary.
2
Upload a document. Select Add New on your Dashboard and transfer a file into the system in one of the following ways: by uploading it from your device or importing from the cloud, web, or internal mail. Then, click Start editing.
3
Edit apa yang dimaksud dengan. Rearrange and rotate pages, add new and changed texts, add new objects, and use other useful tools. When you're done, click Done. You can use the Documents tab to merge, split, lock, or unlock your files.
4
Get your file. Select the name of your file in the docs list and choose your preferred exporting method. You can download it as a PDF, save it in another format, send it by email, or transfer it to the cloud.
pdfFiller makes working with documents easier than you could ever imagine. Register for an account and see for yourself!
Uncompromising security for your PDF editing and eSignature needs
Your private information is safe with pdfFiller. We employ end-to-end encryption, secure cloud storage, and advanced access control to protect your documents and maintain regulatory compliance.
How to fill out apa yang dimaksud dengan

How to fill out apa yang dimaksud dengan
01
To fill out apa yang dimaksud dengan, follow these steps:
02
Start by gathering all the necessary information and documents related to apa yang dimaksud dengan.
03
Read the instructions or guidelines carefully to understand the requirements.
04
Begin filling out the form or providing the necessary information in the designated sections.
05
Double-check and review all the information before submitting it.
06
If required, attach any supporting documents or evidence that may be necessary.
07
Complete any additional steps or follow any specific instructions mentioned in the guidelines.
08
Finally, submit the filled form or provide the required information to the appropriate authority.
Who needs apa yang dimaksud dengan?
01
Apa yang dimaksud dengan is needed by individuals, organizations, or authorities
02
who are seeking specific information, clarification, or understanding about a particular topic or concept.
03
It can be used in various fields such as research, education, law, or any domain where precise definitions or explanations are required.
04
Anyone who wants to have a better understanding or reference to apa yang dimaksud dengan can benefit from it.
Fill
form
: Try Risk Free






For pdfFiller’s FAQs
Below is a list of the most common customer questions. If you can’t find an answer to your question, please don’t hesitate to reach out to us.
How do I modify my apa yang dimaksud dengan in Gmail?
pdfFiller’s add-on for Gmail enables you to create, edit, fill out and eSign your apa yang dimaksud dengan and any other documents you receive right in your inbox. Visit Google Workspace Marketplace and install pdfFiller for Gmail. Get rid of time-consuming steps and manage your documents and eSignatures effortlessly.
Where do I find apa yang dimaksud dengan?
It's simple with pdfFiller, a full online document management tool. Access our huge online form collection (over 25M fillable forms are accessible) and find the apa yang dimaksud dengan in seconds. Open it immediately and begin modifying it with powerful editing options.
Can I edit apa yang dimaksud dengan on an iOS device?
Create, edit, and share apa yang dimaksud dengan from your iOS smartphone with the pdfFiller mobile app. Installing it from the Apple Store takes only a few seconds. You may take advantage of a free trial and select a subscription that meets your needs.
What is apa yang dimaksud dengan?
Apa yang dimaksud dengan refers to...
Who is required to file apa yang dimaksud dengan?
The individuals required to file apa yang dimaksud dengan are...
How to fill out apa yang dimaksud dengan?
To fill out apa yang dimaksud dengan, one must...
What is the purpose of apa yang dimaksud dengan?
The purpose of apa yang dimaksud dengan is...
What information must be reported on apa yang dimaksud dengan?
The information that must be reported on apa yang dimaksud dengan includes...
Fill out your apa yang dimaksud dengan online with pdfFiller!
pdfFiller is an end-to-end solution for managing, creating, and editing documents and forms in the cloud. Save time and hassle by preparing your tax forms online.

Apa Yang Dimaksud Dengan is not the form you're looking for?Search for another form here.
Relevant keywords
Related Forms
If you believe that this page should be taken down, please follow our DMCA take down process
here
.
This form may include fields for payment information. Data entered in these fields is not covered by PCI DSS compliance.